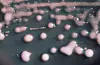
Utslipp av kloakk kobles til økning av resistente bakterier

Klebsiella_pneumoniae_01
Utslipp av kloakk kobles til økning av resistente bakterier
Utslipp av kloakk som ikke er tilstrekkelig behandlet kan forklare en økning av antibiotikaresistente bakterier, resistensgener og antibiotikarester i miljøet. En ny svensk studie tyder på at tarmbakterier fra mennesker nettopp kan være årsaken til økningen av resistente bakterier i det ytre miljø.
De siste årene har myndigheter og fagfolk sett med bekymring på at tradisjonelle medisiner ikke biter på bakterier sm forårsaker infeksjoner. Fenomenet skyldes økende bruk av antibiotika og utslipp av dette, samt at bakterier har evnen til å utvikle motstand(resistens) mot antibiotika.
En ny studie publisert i det renommerte tidsskriftet Nature tyder på at utslipp av tarmbakterier gjennom ikke tilfredsstillende behandlet kloakk kan forklare en økende forekomst av antibiotika motstand ved bakterier i miljøet.
Forskere bl.a. ved Sahlgrenska Instiutet ved Gøteborgs Universitet har vist at et virus som lever på menneskelige tarmbakterier overfører resistensen til bakterier i miljøet.
- Resultatene er viktige for å kunne håndterer helserisiko som er koblet til bakterier i miljøet som er koblet til antibiotikaresistens. Antibiotika er helt klart årsaken til det uvanlige forekomstene av resistens som man finner i nærheten av produsentsteder, mens utslipp av vanlige tarmbakterier er antagelig den viktigste forklaringen på de fleste andre steder, sier professor Larsson gjennom universitetets nyhetstjeneste. Ubehandlet kloakk inneholder tarmbakterier fra mennesker, dyr og miljøet forøvrig samt en blanding av lavere konsentrasjoner av antibiotika. Det er en bekymring for at biologiske filtre kan fungere som forsterkende reaktorer for resistens, all den tid disse bakteriene konstant blir utsatt for antibiotika.
Samtidig vet man at tarmbakterier kan overføre resistens til bakterier i miljøet via virus. Nettopp en svært høy forekomst av virus som lever på tarmbakterier i miljøet tyder på at dette kan forekomme.
Artikkelen kan leses her